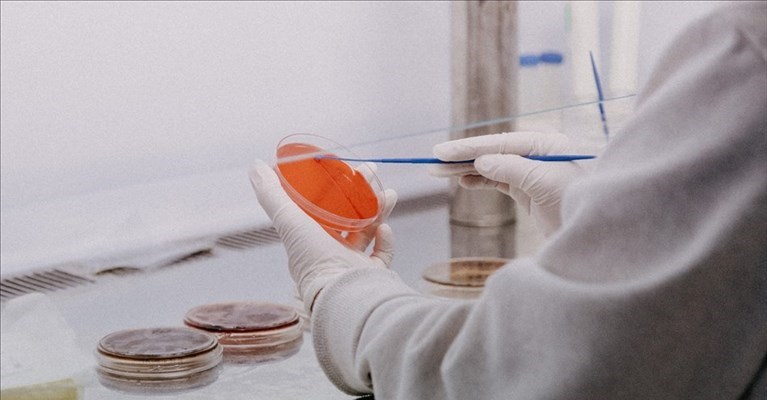
i numeri di oggi

E propone di destinare le risorse all'artigianato, rimasto fuori dal sistema dei ristori. E denuncia: 'Nel 2020 calo delle nuove imprese artigiane del 25%'
Toscana
Tutto è bene quel che finisce bene. Un piccolo capriolo nella giornata di domenica 31…
Marras: 'Saranno comunque usati per ristori, magari per chi non ha potuto partecipare al bando'
Emergenza, L’assessore regionale mette in guardia: “Rischio ancora molto alto”. Il punto sui vaccini
Con un lungo post sui propri canali social Simone Bezzini, assessore al diritto alla salute…
Tutto è bene quel che finisce bene. Un piccolo capriolo nella giornata di ieri si…
Con un lungo post sui propri canali social Simone Bezzini, assessore al diritto alla salute…
Tutto è bene quel che finisce bene. Un piccolo capriolo nella giornata di ieri si…
Con un lungo post sui propri canali social Simone Bezzini, assessore al diritto alla salute…
Come di consueto aggiornamenti odierni sull'emergenza sanitaria in regione dai social del presidente della Regione…
Bollettino del 29 gennaio. Dati stabili in tutta la regione. Bene Lunigiana, Garfagnana, Monte Amiata, Crete Senesi e tutte le località enoturistiche dal Chianti Classico a Montalcino.
Bollettino del 28 gennaio. Dati stabili in tutta la regione. Bene Lunigiana, Garfagnana, Monte Amiata, Crete Senesi e tutte le località enoturistiche dal Chianti Classico a Montalcino.
Ha abbassato il pantografo viaggiando a batteria nel tratto tra la fermata Stazione-Alamanni e Fortezza.…